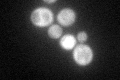
YKL211C
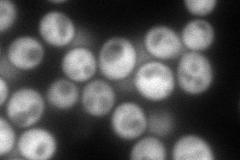
YKL211C
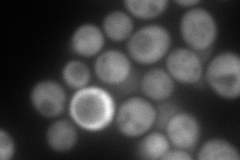
YKL211C
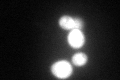
YKL211C
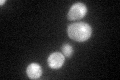
YKL211C

View description
Bifunctional enzyme exhibiting both indole-3-glycerol-phosphate synthase and anthranilate synthase activities, forms multifunctional hetero-oligomeric anthranilate synthase:indole-3-glycerol phosphate synthase enzyme complex with Trp2p
Localization:
Intensity:
Fold change:
Significance:
-
C’ GFP library in SD
cytosol97.44 -
N' NOP1pr-GFP in SD
cytosol159.928 -
N' TEF2pr-mCherry in SD
cytosol234.361 -
N' NATIVEpr-GFP in SD

cytosol71.1993 -
N' TEF2pr-VC and Cyto-VN in SD

#N/A0 -
C’ GFP library in SD+DTT
cytosol119.731.22No -
C’ GFP library in SD+H2O2

cytosol94.30.96No -
C’ GFP library in Starvation Media
nucleus, cytosolN/AN/AYes -
C’ GFP library on the background of Pup2-DaMP

cytosol -
C’ GFP library on the background of CCT mutant

cytosol130.1841.33583No
